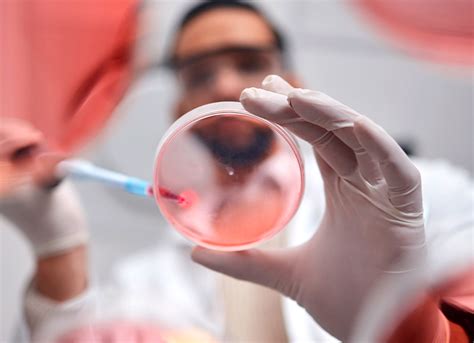
recombinant proteins techniques    guide cocoon bioscience

If you are looking for Recombinant you've come to the right place. We have 31 images about Recombinant including images, pictures, photos, wallpapers, and more. In these page, we also have variety of images available. Such as png, jpg, animated gifs, pic art, logo, black and white, transparent, etc.

Not only Recombinant, you could also find another pics such as
DNA Molecule,
DNA Cloning,
Protein Expression,
Human Growth Hormone,
DNA Cloning Diagram,
DNA Animation,
DNA Structure,
Bacterial Plasmid,
Gene Expression,
DNA Lab Kit,
IGF-2 Protein,
and Anticorps Monoclonaux.
 1600×1067 recombinant proteins genomax from genomax.com.sg
1600×1067 recombinant proteins genomax from genomax.com.sg
 1920×1081 recombinant dna technology from www.genome.gov
1920×1081 recombinant dna technology from www.genome.gov
 374×374 recombinant proteins powered biolegend revvity from www.revvity.com
374×374 recombinant proteins powered biolegend revvity from www.revvity.com
 1022×1024 recombinant protein production clinical trils list labs from listlabs.com
1022×1024 recombinant protein production clinical trils list labs from listlabs.com
 768×431 recombinant dna introduction genetic engineering from studylib.net
768×431 recombinant dna introduction genetic engineering from studylib.net
 400×338 recombinant dna wikipedia from en.wikipedia.org
400×338 recombinant dna wikipedia from en.wikipedia.org
 1000×957 recombinant vector images from www.vectorstock.com
1000×957 recombinant vector images from www.vectorstock.com
 1200×628 recombinant dna technology clearias from www.clearias.com
1200×628 recombinant dna technology clearias from www.clearias.com
 1200×751 recombinant proteins from www.lubio.ch
1200×751 recombinant proteins from www.lubio.ch
 1024×257 recombinant protein advancements proteomics research from bioclone.net
1024×257 recombinant protein advancements proteomics research from bioclone.net
 404×316 recombinant projects logos illustrations from www.behance.net
404×316 recombinant projects logos illustrations from www.behance.net
 474×376 recombinant dna definition formation applications examples from biologynotesonline.com
474×376 recombinant dna definition formation applications examples from biologynotesonline.com
 400×500 news recombinant proteins from biozoomer.com
400×500 news recombinant proteins from biozoomer.com
 1200×768 recombinant dna technology steps application process from www.careerpower.in
1200×768 recombinant dna technology steps application process from www.careerpower.in
 1920×1080 recombinant dna definition from animalia-life.club
1920×1080 recombinant dna definition from animalia-life.club
 474×145 recombinant dna diagram from animalia-life.club
474×145 recombinant dna diagram from animalia-life.club
 640×360 recombinantpptx from www.slideshare.net
640×360 recombinantpptx from www.slideshare.net
 1920×960 recombinant protein production future biotechnology biomatik from www.biomatik.com
1920×960 recombinant protein production future biotechnology biomatik from www.biomatik.com
 2500×1739 tag recombinant protein production bicell scientific from bicellscientific.com
2500×1739 tag recombinant protein production bicell scientific from bicellscientific.com
 1024×522 recombinant dna technology genetics agriculture biotechnology from iastate.pressbooks.pub
1024×522 recombinant dna technology genetics agriculture biotechnology from iastate.pressbooks.pub
 919×615 clinical diagnostic industry benefits recombinant proteins from healthmantain.com
919×615 clinical diagnostic industry benefits recombinant proteins from healthmantain.com
 616×500 recombinant dna technology enzymes biology from notesforbiology.com
616×500 recombinant dna technology enzymes biology from notesforbiology.com
800×580 recombinant proteins techniques guide cocoon bioscience from cocoonbio.com
800×580 recombinant proteins techniques guide cocoon bioscience from cocoonbio.com
 500×514 recombinant dna fundamentals biology biology mit opencourseware from ocw.mit.edu
500×514 recombinant dna fundamentals biology biology mit opencourseware from ocw.mit.edu
 1920×1000 human sirtuin recombinant proteins proteomics products from www.mobitec.com
1920×1000 human sirtuin recombinant proteins proteomics products from www.mobitec.com
 1170×293 recombinant antibodies miltenyi biotec usa from www.miltenyibiotec.com
1170×293 recombinant antibodies miltenyi biotec usa from www.miltenyibiotec.com
 857×612 significance recombinant proteins biotechnology from www.biochain.in
857×612 significance recombinant proteins biotechnology from www.biochain.in
 2048×1536 selection screening recombinant cells expression recombinant from www.slideshare.net
2048×1536 selection screening recombinant cells expression recombinant from www.slideshare.net
 732×955 scheme recombinant experiment scientific from www.researchgate.net
732×955 scheme recombinant experiment scientific from www.researchgate.net
 1920×1920 recombinant proteins benefit clinical diagnostic industry from www.genengnews.com
1920×1920 recombinant proteins benefit clinical diagnostic industry from www.genengnews.com
 857×612 applications recombinant proteins from www.biochain.in
857×612 applications recombinant proteins from www.biochain.in
Don't forget to bookmark Recombinant using Ctrl + D (PC) or Command + D (macos). If you are using mobile phone, you could also use menu drawer from browser. Whether it's Windows, Mac, iOs or Android, you will be able to download the images using download button.